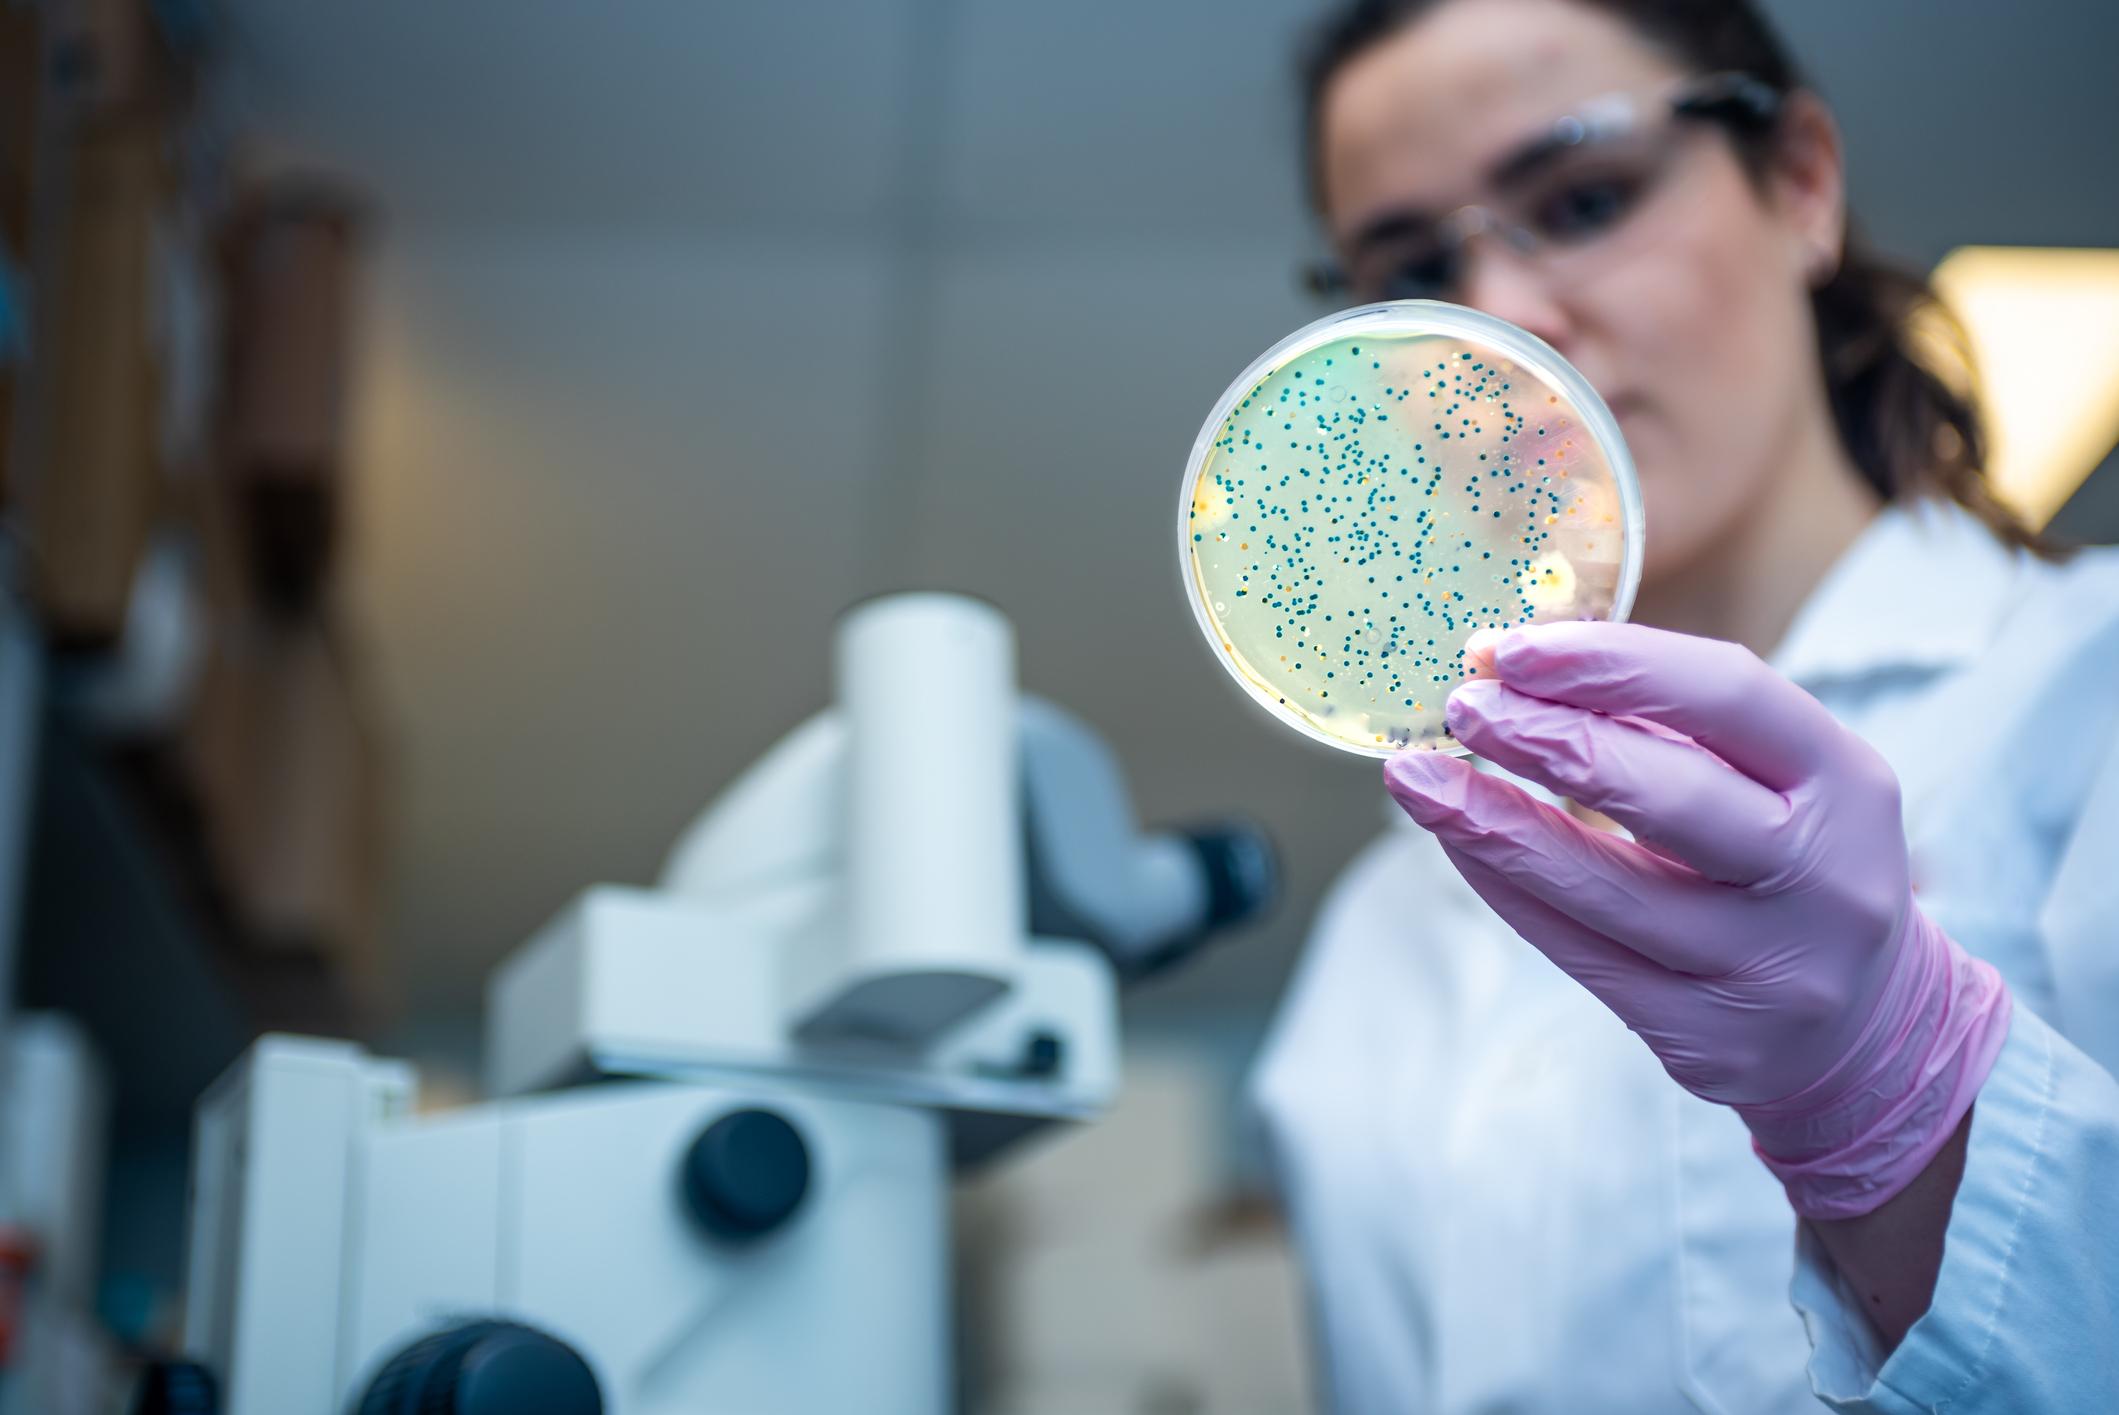

- L’antibiorésistance dite acquise résulte généralement d'un usage inadapté des antibiotiques.
- Une nouvelle classe d’antibiotiques pourrait notamment prévenir des risques de résistance bactérienne.
- Après des tests sur des souris, ces nouveaux antibiotiques se sont révélés très efficaces, notamment pour traiter les infections pulmonaires.
L’antibiorésistance caractérise la capacité d’une bactérie à être insensible à un antibiotique. La résistance bactérienne peut être naturelle, c’est-à-dire que la bactérie est naturellement insensible à certains antibiotiques, ou acquise, autrement dit la bactérie était autrefois sensible à l’antibiotique, mais elle y est devenue résistante. L'antibiorésistance acquise est généralement due à un usage inadapté des antibiotiques chez l'homme comme chez l’animal.
Une nouvelle classe d’antibiotiques pour lutter contre les bactéries résistantes
La communauté scientifique s’active donc à développer de nouveaux antibiotiques pour lutter contre les bactéries résistantes. C’est notamment le cas de chercheurs de l’université de Zurich (Suisse) et de la société Spexix, qui ont modifié la structure chimique de peptides naturels, qui sont des polymères d'acides aminés, afin de développer des molécules antimicrobiennes qui se lient à de nouvelles cibles dans le métabolisme des bactéries.
Dans leur étude publiée dans Science Advance, les chercheurs ont travaillé sur une classe d’antibiotiques très efficaces qui combattent les bactéries Gram-négatives, un groupe de bactéries très dangereux. Leur résistance aux antibiotiques est très élevée en raison de leur double membrane cellulaire. Cette famille de bactéries comprend notamment les entérobactéries résistantes aux carbapénèmes.
Des recherches supplémentaires avant les premiers tests sur l’homme
Lors de la recherche, les scientifiques ont étudié la thanatine, un peptide naturel, permettant aux insectes de se protéger et de lutter contre les infections. La thanatine perturbe un important pont de transport du lipopolysaccharide entre la membrane externe et la membrane interne des bactéries Gram négatives.
L’équipe a modifié la structure chimique de la thanatine afin d'améliorer les caractéristiques du peptide. "Pour ce faire, des analyses structurales étaient indispensables", a indiqué Oliver Zerbe, co-auteur de l’étude, chimistre et responsable des installations de résonance magnétique nucléaire à l'université de Zurich. Les scientifiques ont ensuite assemblé synthétiquement les différents composants du pont de transport bactérien, et ont utilisé la résonance magnétique nucléaire pour visualiser où et comment la thanatine se lie au pont de transport et le perturbe. Grâce à ces données, les chercheurs ont déterminé les modifications chimiques nécessaires, afin de renforcer les effets antibactériens du peptide.
Pour les besoins de cette recherche, les peptides synthétiques ont ensuite été testés sur des souris touchées par des infections bactériennes. "Les nouveaux antibiotiques se sont révélés très efficaces, notamment pour traiter les infections pulmonaires (…) Ils sont également très efficaces contre les entérobactéries résistantes aux carbapénèmes, où la plupart des autres antibiotiques échouent. En outre, les peptides nouvellement développés ne sont pas toxiques ou nocifs pour les reins, et ils se sont également révélés stables dans le sang sur une longue période", a noté Oliver Zerbe. Des études précliniques seront toutefois nécessaires avant de débuter les premiers tests sur l’homme.